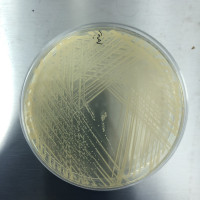
产品图

深圳市领先医疗服务有限公司免费会员
公司介绍
一、公司简介:
公司拥有一支60余人的专业队伍,所学专业涵盖生物医学、材料学、微生物学、免疫学、药理学、动物医学、医学影像、临床检验、病理学等,其中40%以上人员拥有硕士以上学历、10%以上具有海外留学工作经历、30%拥有10年以上的医疗器械行业工作经验。公司总 部位于深圳高新技术产业园区,按照ISO/IEC17025和美国21 CFR Part 58标准建立了大型动物实验中心,配有万级微创外科手术室、介入导管室和介入手术培训室。并拥有病理切片、生物相容性、药代和化学分析、生物力学、 材料表征等十多个专业实验室,所用仪器设备均为国内外高端知名品牌,实验室设备总投资逾6000万元。
二、服务范围:
我们为心血管植入/介入器械、含药器械、骨科植入器械、呼吸科、超声刀、内窥镜、口腔齿科眼科等植入/介入器械的研究提供动物实验(包括器械植入、临床检验、病理分析和药物代谢分析等),生物安全性测试及评估,产品疲劳测试等;也可以与科研 机构开展项目合作,为医生提供新器械和新术式的培训,为高校提供教学实践及研究生联合培养。提供动物实验方案制定和策略、动物实验及各项指标检测、科研实验、医师手术操作练习、实验室的建立咨询等多个模块的服务。
同时也提供GMP&ISO13485质量体系建立、洁净室设计、设计验证、过程确认(清洗、包装、灭菌等)及设计确认(动物实验)、创新申报、CE认证、NMPA注册、FDA注册、临床评价(包括CE临床评价及国内同品种临床评价)等咨询服务。全球法规注册申报等咨询服务。缩短产品研发周期,加速产品合规上市。
公司拥有一支60余人的专业队伍,所学专业涵盖生物医学、材料学、微生物学、免疫学、药理学、动物医学、医学影像、临床检验、病理学等,其中40%以上人员拥有硕士以上学历、10%以上具有海外留学工作经历、30%拥有10年以上的医疗器械行业工作经验。公司总 部位于深圳高新技术产业园区,按照ISO/IEC17025和美国21 CFR Part 58标准建立了大型动物实验中心,配有万级微创外科手术室、介入导管室和介入手术培训室。并拥有病理切片、生物相容性、药代和化学分析、生物力学、 材料表征等十多个专业实验室,所用仪器设备均为国内外高端知名品牌,实验室设备总投资逾6000万元。
二、服务范围:
我们为心血管植入/介入器械、含药器械、骨科植入器械、呼吸科、超声刀、内窥镜、口腔齿科眼科等植入/介入器械的研究提供动物实验(包括器械植入、临床检验、病理分析和药物代谢分析等),生物安全性测试及评估,产品疲劳测试等;也可以与科研 机构开展项目合作,为医生提供新器械和新术式的培训,为高校提供教学实践及研究生联合培养。提供动物实验方案制定和策略、动物实验及各项指标检测、科研实验、医师手术操作练习、实验室的建立咨询等多个模块的服务。
同时也提供GMP&ISO13485质量体系建立、洁净室设计、设计验证、过程确认(清洗、包装、灭菌等)及设计确认(动物实验)、创新申报、CE认证、NMPA注册、FDA注册、临床评价(包括CE临床评价及国内同品种临床评价)等咨询服务。全球法规注册申报等咨询服务。缩短产品研发周期,加速产品合规上市。
供应产品
详细信息
| 公司名称 | 深圳市领先医疗服务有限公司 | 企业类型 | 民营 |
| 经营模式 | 企业地区 | 广东-深圳市-南山区 | |
| 经营地址 | 深圳市南山区粤海街道科技南十二路22号先健科技大厦7楼701 | 主要产品 | 大动物实验,生物相容性测试,医疗器械性能评估,产品注册法规咨询 |
| 公司成立时间 | 2016 | 公司网址 | http://www.advancedmed.cn/ |
免责声明:以上所展示的信息由企业自行提供,内容的真实性、准确性和合法性由发布企业负责,丁香园对此不承担任何保证责任。